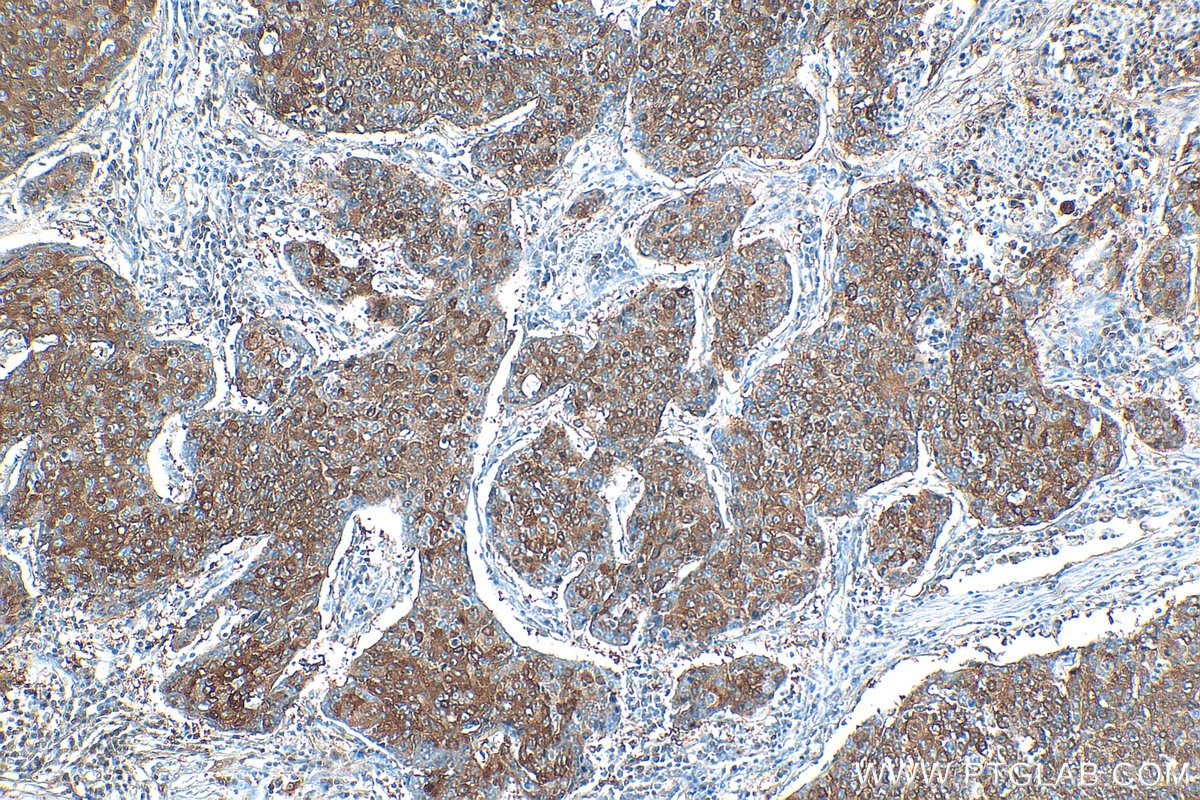
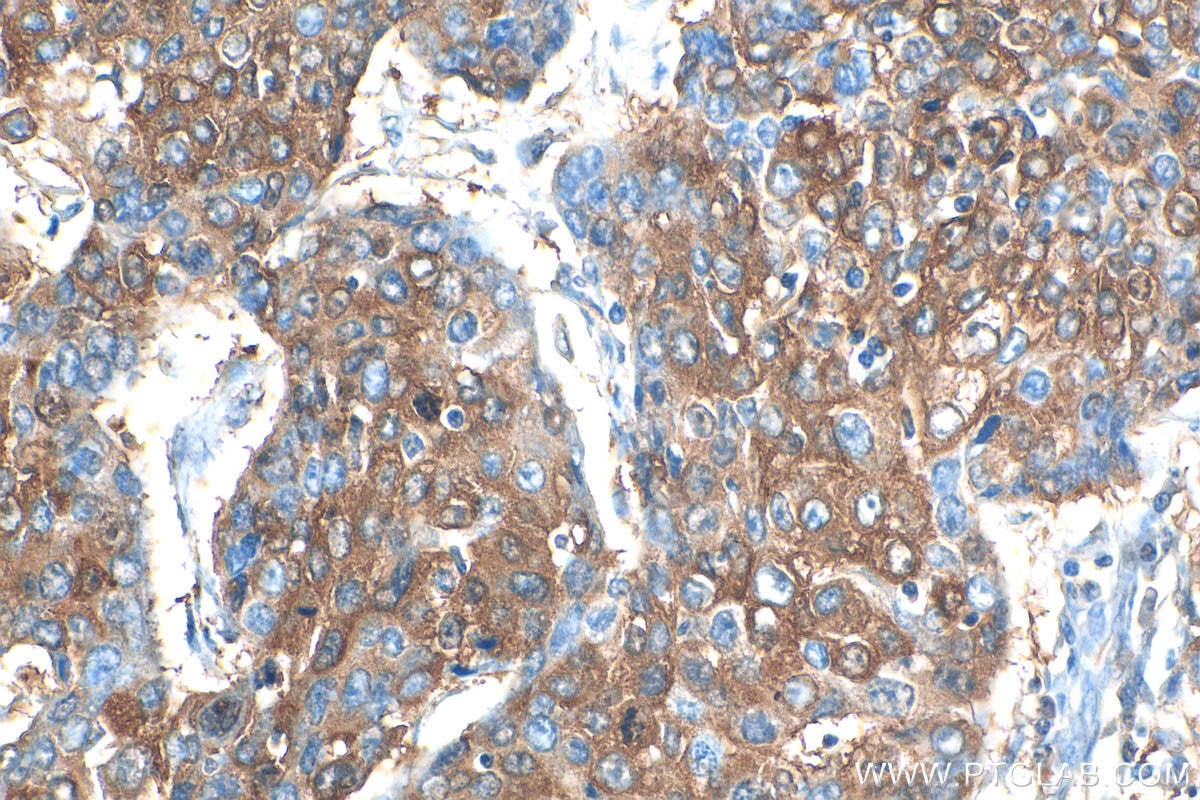

Tested Applications
| Positive WB detected in | mouse brain tissue, mouse placenta tissue, rat brain tissue |
| Positive IP detected in | rat brain tissue |
| Positive IHC detected in | mouse brain tissue, human lung cancer tissue, rat brain tissue Note: suggested antigen retrieval with TE buffer pH 9.0; (*) Alternatively, antigen retrieval may be performed with citrate buffer pH 6.0 |
| Positive IF-P detected in | mouse brain tissue |
| Positive IF/ICC detected in | Neuro-2a cells |
Recommended dilution
| Application | Dilution |
|---|---|
| Western Blot (WB) | WB : 1:500-1:1000 |
| Immunoprecipitation (IP) | IP : 0.5-4.0 ug for 1.0-3.0 mg of total protein lysate |
| Immunohistochemistry (IHC) | IHC : 1:200-1:800 |
| Immunofluorescence (IF)-P | IF-P : 1:50-1:500 |
| Immunofluorescence (IF)/ICC | IF/ICC : 1:50-1:500 |
| It is recommended that this reagent should be titrated in each testing system to obtain optimal results. | |
| Sample-dependent, Check data in validation data gallery. | |
Published Applications
| WB | See 32 publications below |
| IHC | See 6 publications below |
| IF | See 31 publications below |
Product Information
20747-1-AP targets CHAT in WB, IHC, IF/ICC, IF-P, IP, ELISA applications and shows reactivity with human, mouse, rat samples.
| Tested Reactivity | human, mouse, rat |
| Cited Reactivity | human, mouse, rat |
| Host / Isotype | Rabbit / IgG |
| Class | Polyclonal |
| Type | Antibody |
| Immunogen |
Peptide Predict reactive species |
| Full Name | choline acetyltransferase |
| Calculated Molecular Weight | 83 kDa |
| Observed Molecular Weight | 47-50 kDa, 66-70 kDa |
| GenBank Accession Number | NM_020549 |
| Gene Symbol | CHAT |
| Gene ID (NCBI) | 1103 |
| RRID | AB_10898169 |
| Conjugate | Unconjugated |
| Form | Liquid |
| Purification Method | Antigen affinity purification |
| UNIPROT ID | P28329 |
| Storage Buffer | PBS with 0.02% sodium azide and 50% glycerol, pH 7.3. |
| Storage Conditions | Store at -20°C. Stable for one year after shipment. Aliquoting is unnecessary for -20oC storage. 20ul sizes contain 0.1% BSA. |
Background Information
CHAT (choline acetyltransferase) belongs to the carnitine/choline acetyltransferase family. It catalyzes the reversible synthesis of acetylcholine (ACh) from acetyl CoA and choline at cholinergic synapses. Defects in CHAT are the cause of congenital myasthenic syndrome with episodic apnea (CMSEA). CHAT is known to be present exclusively in the cytoplasm of cholinergic neurons and anti-CHAT antibody has been considered as the best marker for cholinergic neurons. Human CHAT gene generates multiple mRNA splice variants (PMID: 10861222). All these variants possess start codons for translation of 70 kDa cChAT protein (isoform 1). The M variant has an additional start codon for 83 kDa cChAT protein (isoform 2), which has been found in nuclei of neuronal cells in human CNS; and the S variant has another codon for 74 kDa cChAT protein (isoform 3). Besides, CHAT includes a short exon-skipping splice variant (peripheral type CHAT) pCHAT encoding 40-55 kDa (PMID: 31040770, 29759072). This antibody can recognize both pCHAT and cCHAT.
Protocols
| Product Specific Protocols | |
|---|---|
| IF protocol for CHAT antibody 20747-1-AP | Download protocol |
| IHC protocol for CHAT antibody 20747-1-AP | Download protocol |
| IP protocol for CHAT antibody 20747-1-AP | Download protocol |
| WB protocol for CHAT antibody 20747-1-AP | Download protocol |
| Standard Protocols | |
|---|---|
| Click here to view our Standard Protocols |
Publications
| Species | Application | Title |
|---|---|---|
Adv Mater Noninvasive Optogenetics Realized by iPSC-Derived Tentacled Carrier in Alzheimer's Disease Treatment | ||
Cell Stem Cell Deriving Schwann cells from hPSCs enables disease modeling and drug discovery for diabetic peripheral neuropathy | ||
Nat Chem Biol Small molecule agonist of mitochondrial fusion repairs mitochondrial dysfunction | ||
PLoS Biol LSM12-EPAC1 defines a neuroprotective pathway that sustains the nucleocytoplasmic RAN gradient. | ||
Stem Cells Transl Med Premigratory neural crest stem cells generate enteric neurons populating the mouse colon and regulating peristalsis in tissue-engineered intestine. | ||
J Neurosci Myocardial Infarction Causes Transient Cholinergic Transdifferentiation of Cardiac Sympathetic Nerves via gp130. |
Reviews
The reviews below have been submitted by verified Proteintech customers who received an incentive for providing their feedback.
FH Ashley (Verified Customer) (12-16-2025) | Thank you!
|
FH Jerome (Verified Customer) (07-20-2022) | we followed this protocol : antigen retrieval buffer: citrate pH 6 (DAKO S1699) wash in TBS 1X Blocking buffer TBS1x +Serum Goat 5%, 1H at RT Primary and secondary antibody diluted in TBS1X Wash primary antibody TBS1X 0.2%tween Secondary antibody GAR 594 ref A11012 Wash secondary antibody TBS1X 0.2%tween Unfortunately, it doesn't work under these conditions.
|
FH Xin (Verified Customer) (01-23-2022) | Good performance in WB (around 70 kd).
![]() |